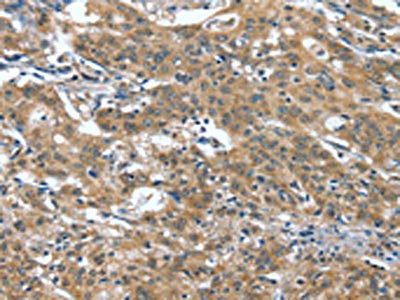

DTX1 Antibody
-
中文名稱:DTX1兔多克隆抗體
-
貨號(hào):CSB-PA199144
-
規(guī)格:¥1100
-
圖片:
-
The image on the left is immunohistochemistry of paraffin-embedded Human cervical cancer tissue using CSB-PA199144(DTX1 Antibody) at dilution 1/40, on the right is treated with synthetic peptide. (Original magnification: ×200)
-
The image on the left is immunohistochemistry of paraffin-embedded Human gastric cancer tissue using CSB-PA199144(DTX1 Antibody) at dilution 1/40, on the right is treated with synthetic peptide. (Original magnification: ×200)
-
-
其他:
產(chǎn)品詳情
-
Uniprot No.:
-
基因名:
-
別名:Deltex 1; E3 ubiquitin ligase antibody; Deltex antibody; Deltex homolog 1 (Drosophila) antibody; Deltex homolog 1 antibody; Deltex protein 1 antibody; Deltex-1 antibody; Deltex1 antibody; dtx1 antibody; DTX1_HUMAN antibody; E3 ubiquitin protein ligase DTX1 antibody; E3 ubiquitin-protein ligase DTX1 antibody; FXI-T1 antibody; Fxit 1 antibody; Fxit1 antibody; hDTX1 antibody; hDx 1 antibody; mDTX1 antibody; Protein deltex 1 antibody; Protein deltex-1 antibody
-
宿主:Rabbit
-
反應(yīng)種屬:Human,Mouse
-
免疫原:Synthetic peptide of Human DTX1
-
免疫原種屬:Homo sapiens (Human)
-
標(biāo)記方式:Non-conjugated
-
抗體亞型:IgG
-
純化方式:Antigen affinity purification
-
濃度:It differs from different batches. Please contact us to confirm it.
-
保存緩沖液:-20°C, pH7.4 PBS, 0.05% NaN3, 40% Glycerol
-
產(chǎn)品提供形式:Liquid
-
應(yīng)用范圍:ELISA,IHC
-
推薦稀釋比:
Application Recommended Dilution ELISA 1:2000-1:5000 IHC 1:50-1:200 -
Protocols:
-
儲(chǔ)存條件:Upon receipt, store at -20°C or -80°C. Avoid repeated freeze.
-
貨期:Basically, we can dispatch the products out in 1-3 working days after receiving your orders. Delivery time maybe differs from different purchasing way or location, please kindly consult your local distributors for specific delivery time.
-
用途:For Research Use Only. Not for use in diagnostic or therapeutic procedures.
相關(guān)產(chǎn)品
靶點(diǎn)詳情
-
功能:Functions as a ubiquitin ligase protein in vivo, mediating ubiquitination and promoting degradation of MEKK1, suggesting that it may regulate the Notch pathway via some ubiquitin ligase activity. Regulator of Notch signaling, a signaling pathway involved in cell-cell communications that regulates a broad spectrum of cell-fate determinations. Mainly acts as a positive regulator of Notch, but it also acts as a negative regulator, depending on the developmental and cell context. Mediates the antineural activity of Notch, possibly by inhibiting the transcriptional activation mediated by MATCH1. Involved in neurogenesis, lymphogenesis and myogenesis, and may also be involved in MZB (Marginal zone B) cell differentiation. Promotes B-cell development at the expense of T-cell development, suggesting that it can antagonize NOTCH1.
-
基因功能參考文獻(xiàn):
- Deltex-1 mutations predict poor survival in diffuse large B-cell lymphoma PMID: 28183850
- PI5P4Kgamma positively regulates the DTX1-mediated Notch pathway by promoting receptor recycling PMID: 29440432
- Data indicate that decreased expression of deltex E3 ubiquitin ligase 1 (DTX1) in head and neck squamous cell carcinoma (HNSCC) tumors maybe associated with NOTCH pathway activation and increased migration potential. PMID: 28146432
- Two SNPs (rs2384077 and rs10744794) in an intron of DTX1 and the linkage disequilibrium (LD) block are significantly associated with the immune response to HBV vaccination. PMID: 26894927
- this study reports the identification of two new hGIP-interacting partners, DTX1 and STAU1. PMID: 23395680
- characterization of two genes expressed in centroblasts of human tonsils: deltex (Drosophila) homolog 1 (DTX1), which is related to the Notch pathway and a new Kelch-like protein, KLHL6 PMID: 12617994
- It is reported that BBAP and the human family of DTX proteins (DTX1, DTX2, and DTX3) function as E3 ligases based on their capacity for self-ubiquitination. PMID: 12670957
顯示更多
收起更多
-
亞細(xì)胞定位:Cytoplasm. Nucleus. Note=Predominantly cytoplasmic. Associates with endocytic vesicles. Partially nuclear.
-
蛋白家族:Deltex family
-
組織特異性:Widely expressed. Strongly expressed in blood vessel. Also expressed in embryonic nervous system, pancreas, lung, adrenal gland, digestive tube and muscles. Expressed in MZB cells and developing B- and T-cells.
-
數(shù)據(jù)庫鏈接:
Most popular with customers
-
-
YWHAB Recombinant Monoclonal Antibody
Applications: ELISA, WB, IHC, IF, FC
Species Reactivity: Human, Mouse, Rat
-
Phospho-YAP1 (S127) Recombinant Monoclonal Antibody
Applications: ELISA, WB, IHC
Species Reactivity: Human
-
-
-
-
-